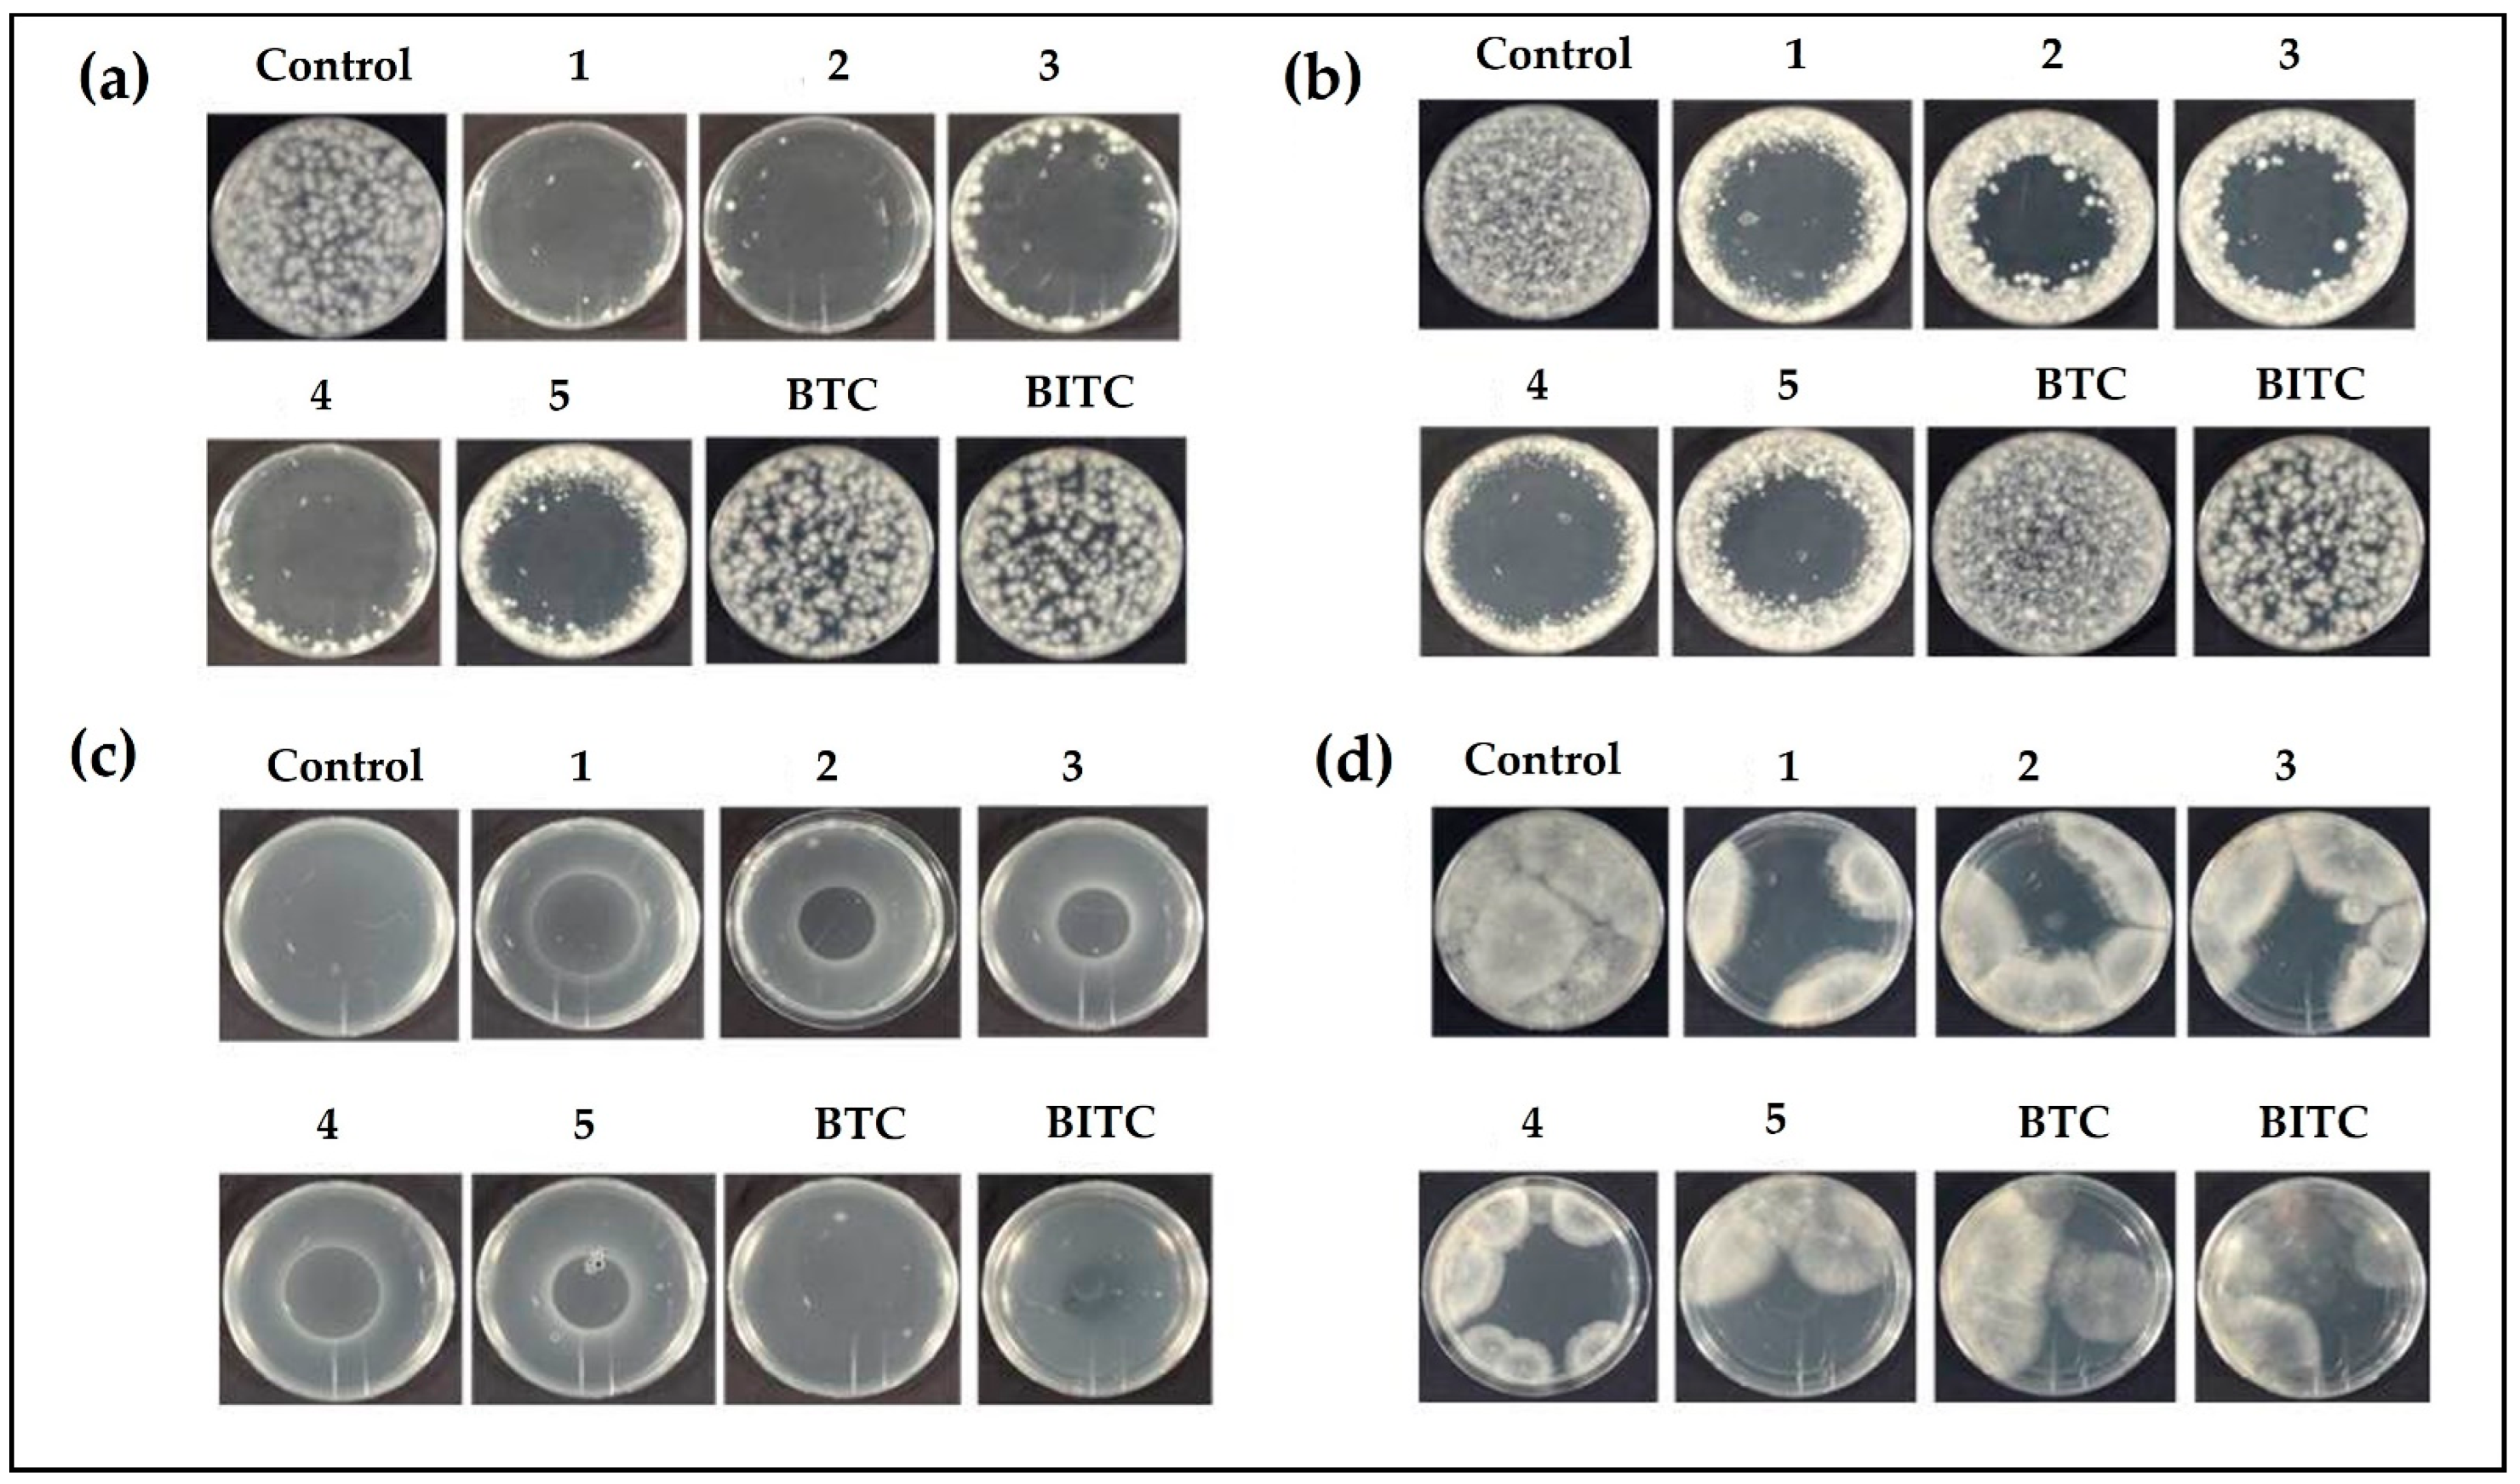
Antibiotics 12 00290 g005 Antibiotics 12 00290 g005

To Cut the Mustard: Antimicrobial Activity of Selenocyanates on the Plate and in the Gas Phase
Abstract
1. Introduction
2. Materials and Methods
2.1. Selenocyanates and (Iso)Thiocyantes
2.2. Organisms and Media
2.3. Assessment of Antibacterial Activity
2.4. Drop Test
2.5. Inhibition Zone Assay
2.6. Determination of Antibacterial Activity of Compounds in the Gas Phase
2.7. Evaluation of the Antifungal Activity
2.8. Determination of Antifungal Activity of Compounds in the Gas Phase
2.9. Calculation of Vapor Pressure
2.10. Statistical Analysis
3. Results and Discussion
3.1. Antibacterial Activity
3.2. Antibacterial Activity via the Gas Phase Assay
3.3. Determination of Zone of Fungal Growth
4. Conclusions
Author Contributions
Funding
Institutional Review Board Statement
Informed Consent Statement
Data Availability Statement
Acknowledgments
Conflicts of Interest
References
- Karmaker, P.G.; Huo, F. Organic Selenocyanates: Rapid Advancements and Applicationsin the Field of Organic Chemistry. Asian J. Org. Chem. 2022, 11, e202200226. [Google Scholar] [CrossRef]
- Kharma, A.; Misak, A.; Grman, M.; Brezova, V.; Kurakova, L.; Baráth, P.; Jacob, C.; Chovanec, M.; Ondrias, K.; Domínguez-Álvarez, E. Release of reactive selenium species from phthalic selenoanhydride in the presence of hydrogen sulfide and glutathione with implications for cancer research. New J. Chem. 2019, 43, 11771–11783. [Google Scholar] [CrossRef]
- Rendekova, J.; Vlasakova, D.; Arsenyan, P.; Vasiljeva, J.; Nasim, M.J.; Witek, K.; Dominguez-Alvarez, E.; Zeslawska, E.; Manikova, D.; Tejchman, W.; et al. The Selenium-Nitrogen Bond as Basis for Reactive Selenium Species with Pronounced Antimicrobial Activity. Curr. Org. Synth. 2018, 14, 1082–1090. [Google Scholar] [CrossRef]
- Du, P.; Viswanathan, U.M.; Xu, Z.; Ebrahimnejad, H.; Hanf, B.; Burkholz, T.; Schneider, M.; Bernhardt, I.; Kirsch, G.; Jacob, C. Synthesis of amphiphilic seleninic acid derivatives with considerable activity against cellular membranes and certain pathogenic microbes. J. Hazard. Mater. 2014, 269, 74–82. [Google Scholar] [CrossRef] [PubMed]
- El-Bayoumy, K.; Upadhyaya, P.; Date, V.; Sohn, O.S.; Fiala, E.S.; Reddy, B. Metabolism of [14C]benzyl selenocyanate in the F344 rat. Chem. Res. Toxicol. 1991, 4, 560–565. [Google Scholar] [CrossRef]
- Riel, A.M.S.; Huynh, H.-T.; Jeannin, O.; Berryman, O.; Fourmigué, M. Organic Selenocyanates as Halide Receptors: From Chelation to One-Dimensional Systems. Cryst. Growth Des. 2019, 19, 1418–1425. [Google Scholar] [CrossRef]
- Kostić, M.D.; Divac, V.M. Diselenides and Selenocyanates as Versatile Precursors for the Synthesis of Pharmaceutically Relevant Compounds. Curr. Org. Synth. 2022, 19, 317–330. [Google Scholar] [CrossRef]
- Plano, D.; Baquedano, Y.; Moreno-Mateos, D.; Font, M.; Jiménez-Ruiz, A.; Palop, J.A.; Sanmartín, C. Selenocyanates and diselenides: A new class of potent antileishmanial agents. Eur. J. Med. Chem. 2011, 46, 3315–3323. [Google Scholar] [CrossRef]
- Ramos-Inza, S.; Henriquez-Figuereo, A.; Moreno, E.; Berzosa, M.; Encío, I.; Plano, D.; Sanmartín, C. Unveiling a New Selenocyanate as a Multitarget Candidate with Anticancer, Antileishmanial and Antibacterial Potential. Molecules 2022, 27, 7477. [Google Scholar] [CrossRef]
- Martín-Escolano, R.; Molina-Carreño, D.; Plano, D.; Espuelas, S.; Rosales, M.J.; Moreno, E.; Aydillo, C.; Sanmartín, C.; Sánchez-Moreno, M.; Marín, C. Library of Selenocyanate and Diselenide Derivatives as In Vivo Antichagasic Compounds Targeting Trypanosoma cruzi Mitochondrion. Pharmaceuticals 2021, 14, 419. [Google Scholar] [CrossRef]
- Frizon, T.E.A.; Cararo, J.H.; Saba, S.; Dal-Pont, G.C.; Michels, M.; Braga, H.C.; Pimentel, T.; Dal-Pizzol, F.; Valvassori, S.S.; Rafique, J. Synthesis of Novel Selenocyanates and Evaluation of Their Effect in Cultured Mouse Neurons Submitted to Oxidative Stress. Oxidative Med. Cell. Longev. 2020, 2020, 5417024. [Google Scholar] [CrossRef] [PubMed]
- Facompre, N.D.; El-Bayoumy, K.; Sun, Y.-W.; Pinto, J.T.; Sinha, R. 1,4-phenylenebis(methylene)selenocyanate but not selenomethionine inhibits androgen receptor and Akt signaling in human prostate cancer cells. Cancer Prev. Res. Phila. Pa 2010, 3, 975–984. [Google Scholar] [CrossRef]
- Chen, K.-M.; Sacks, P.G.; Spratt, T.E.; Lin, J.-M.; Boyiri, T.; Schwartz, J.; Richie, J.P.; Calcagnotto, A.; Das, A.; Bortner, J.; et al. Modulations of benzo[a]pyrene-induced DNA adduct, cyclin D1 and PCNA in oral tissue by 1,4-phenylenebis(methylene)selenocyanate. Biochem. Biophys. Res. Commun. 2009, 383, 151–155. [Google Scholar] [CrossRef] [PubMed]
- Nasim, M.J.; Witek, K.; Kincses, A.; Abdin, A.Y.; Żesławska, E.; Marć, M.A.; Gajdács, M.; Spengler, G.; Nitek, W.; Latacz, G.; et al. Pronounced activity of aromatic selenocyanates against multidrug resistant ESKAPE bacteria. New J. Chem. 2019, 43, 6021–6031. [Google Scholar] [CrossRef]
- Mejía-Garibay, B.; Palou, E.; López-Malo, A. Composition, Diffusion, and Antifungal Activity of Black Mustard (Brassica nigra) Essential Oil When Applied by Direct Addition or Vapor Phase Contact. J. Food Prot. 2015, 78, 843–848. [Google Scholar] [CrossRef] [PubMed]
- Manyes, L.; Luciano, F.B.; Mañes, J.; Meca, G. In vitro antifungal activity of allyl isothiocyanate (AITC) against Aspergillus parasiticus and Penicillium expansum and evaluation of the AITC estimated daily intake. Food Chem. Toxicol. 2015, 83, 293–299. [Google Scholar] [CrossRef] [PubMed]
- Nazareth, T.d.M.; Quiles, J.M.; Torrijos, R.; Luciano, F.B.; Mañes, J.; Meca, G. Antifungal and antimycotoxigenic activity of allyl isothiocyanate on barley under different storage conditions. LWT 2019, 112, 108237. [Google Scholar] [CrossRef]
- Lin, C.-M.; Preston, J.F., III; Wei, C.-I. Antibacterial Mechanism of Allyl Isothiocyanate. J. Food Prot. 2000, 63, 727–734. [Google Scholar] [CrossRef] [PubMed]
- Tsao, R.; Peterson, C.J.; Coats, J.R. Glucosinolate breakdown products as insect fumigants and their effect on carbon dioxide emission of insects. BMC Ecol. 2002, 2, 5. [Google Scholar] [CrossRef]
- Chandler, J.D.; Min, E.; Huang, J.; McElroy, C.S.; Dickerhof, N.; Mocatta, T.; Fletcher, A.A.; Evans, C.M.; Liang, L.; Patel, M.; et al. Antiinflammatory and Antimicrobial Effects of Thiocyanate in a Cystic Fibrosis Mouse Model. Am. J. Respir. Cell Mol. Biol. 2015, 53, 193–205. [Google Scholar] [CrossRef]
- Sarfraz, M.; Nasim, M.J.; Jacob, C.; Gruhlke, M.C.H. Yeast Chemogenetic Screening as a Tool to Unravel the Antifungal Mode of Action of Two Selected Selenocyanates. Appl. Sci. 2019, 9, 3728. [Google Scholar] [CrossRef]
- Riague, E.H.; Guillemin, J.-C. Synthesis and Characterization of Allylic and Propargylic Selenols. Organometallics 2002, 21, 68–73. [Google Scholar] [CrossRef]
- Sarfraz, M.; Griffin, S.; Gabour Sad, T.; Alhasan, R.; Nasim, M.J.; Irfan Masood, M.; Schäfer, K.H.; Ejike, C.E.C.C.; Keck, C.M.; Jacob, C.; et al. Milling the Mistletoe: Nanotechnological Conversion of African Mistletoe (Loranthus micranthus) Intoantimicrobial Materials. Antioxidants 2018, 7, 60. [Google Scholar] [CrossRef] [PubMed]
- Griffin, S.; Sarfraz, M.; Hartmann, S.F.; Pinnapireddy, S.R.; Nasim, M.J.; Bakowsky, U.; Keck, C.M.; Jacob, C. Resuspendable Powders of Lyophilized Chalcogen Particles with Activity against Microorganisms. Antioxidants 2018, 7, 23. [Google Scholar] [CrossRef]
- Estevam, E.C.; Griffin, S.; Nasim, M.J.; Denezhkin, P.; Schneider, R.; Lilischkis, R.; Dominguez-Alvarez, E.; Witek, K.; Latacz, G.; Keck, C.; et al. Natural selenium particles from Staphylococcus carnosus: Hazards or particles with particular promise? J. Hazard. Mater. 2017, 324, 22–30. [Google Scholar] [CrossRef] [PubMed]
- Leontiev, R.; Hohaus, N.; Jacob, C.; Gruhlke, M.C.H.; Slusarenko, A.J. A Comparison of the Antibacterial and Antifungal Activities of Thiosulfinate Analogues of Allicin. Sci. Rep. 2018, 8, 6763. [Google Scholar] [CrossRef]
- Leontiev, R.; Slusarenko, A.J. Finding the Starting Point for Mode-of-Action Studies of Novel Selenium Compounds: Yeast as a Genetic Toolkit. Curr. Org. Synth. 2018, 14, 1102–1108. [Google Scholar] [CrossRef]
- Perello, A.E.; Noll, U.; Slusarenko, A.J. In vitro efficacy of garlic extract to control fungal pathogens of wheat. J. Med. Plants Res. 2013, 7, 1809–1817. [Google Scholar]
- Sarfraz, M.; Nasim, M.J.; Jacob, C.; Gruhlke, M.C.H. Efficacy of Allicin against Plant Pathogenic Fungi and Unveiling the Underlying Mode of Action Employing Yeast Based Chemogenetic Profiling Approach. Appl. Sci. 2020, 10, 2563. [Google Scholar] [CrossRef]
- ChemSpider Search and Share Chemistry. Available online: http://www.chemspider.com/ (accessed on 18 November 2022).
- Fan, J.; Crooks, C.; Creissen, G.; Hill, L.; Fairhurst, S.; Doerner, P.; Lamb, C. Pseudomonas sax genes overcome aliphatic isothiocyanate-mediated non-host resistance in Arabidopsis. Science 2011, 331, 1185–1188. [Google Scholar] [CrossRef]
- Sakata, N.; Haraguchi, T.; Masuo, S.; Ishiga, T.; Ishiga, Y. Pseudomonas cannabina pv. alisalensis Virulence Factors Are Involved in Resistance to Plant-Derived Antimicrobials during Infection. Plants 2022, 11, 1742. [Google Scholar] [CrossRef]
- Schumacher, A.; Vranken, T.; Malhotra, A.; Arts, J.J.C.; Habibovic, P. In vitro antimicrobial susceptibility testing methods: Agar dilution to 3D tissue-engineered models. Eur. J. Clin. Microbiol. Infect. Dis. 2018, 37, 187–208. [Google Scholar] [CrossRef] [PubMed]
- Haase, H.; Jordan, L.; Keitel, L.; Keil, C.; Mahltig, B. Comparison of methods for determining the effectiveness of antibacterial functionalized textiles. PLoS ONE 2017, 12, e0188304. [Google Scholar] [CrossRef] [PubMed]
- Benzyl Selenocyanate|C8H7NSe|ChemSpider. Available online: http://www.chemspider.com/Chemical-Structure.91670.html?rid=72398506-ac7e-4ffb-b6a9-0253f0650e5d (accessed on 18 November 2022).
- 4-Methylbenzyl Selenocyanate|C9H9NSe|ChemSpider. Available online: http://www.chemspider.com/Chemical-Structure.2036271.html?rid=46b02759-fef7-48eb-9739-ff8d7712ea92 (accessed on 18 November 2022).
- 4-Fluorobenzyl Selenocyanate|C8H6FNSe|ChemSpider. Available online: http://www.chemspider.com/Chemical-Structure.2036275.html?rid=201bce8d-b40b-4b3b-99da-f140a1d89bbb (accessed on 18 November 2022).
- Benzyl Isothiocyanate|C8H7NS|ChemSpider. Available online: http://www.chemspider.com/Chemical-Structure.2256.html?rid=d18c2421-eb2f-41ff-a22b-5826bf5b8117 (accessed on 18 November 2022).
- Bradley, J.-C.; Williams, A.; Lang, A. Jean-Claude Bradley Open Melting Point Dataset; Figshare: London, UK, 2014; 2225265 Bytes. [Google Scholar] [CrossRef]
- Duan, X.; Qin, D.; Li, H.; Zhang, T.; Han, Y.; Huang, Y.Q.; He, D.; Wu, K.; Chai, X.; Chen, C. Study of antimicrobial activity and mechanism of vapor-phase cinnamaldehyde for killing Escherichia coli based on fumigation method. Front. Nutr. 2022, 9, 1040152. [Google Scholar] [CrossRef]
- Plaszkó, T.; Szűcs, Z.; Vasas, G.; Gonda, S. Interactions of fungi with non-isothiocyanate products of the plant glucosinolate pathway: A review on product formation, antifungal activity, mode of action and biotransformation. Phytochemistry 2022, 200, 113245. [Google Scholar] [CrossRef] [PubMed]
- Radulović, N.S.; Dekić, M.S.; Stojanović-Radić, Z.Z. Antimicrobial volatile glucosinolate autolysis products from Hornungia petraea (L.) Rchb. (Brassicaceae). Phytochem. Lett. 2012, 5, 351–357. [Google Scholar] [CrossRef]
- Ren, Z.; Li, Y.; Fang, W.; Yan, D.; Huang, B.; Zhu, J.; Wang, X.; Wang, X.; Wang, Q.; Guo, M.; et al. Evaluation of allyl isothiocyanate as a soil fumigant against soil-borne diseases in commercial tomato (Lycopersicon esculentum Mill.) production in China. Pest Manag. Sci. 2018, 74, 2146–2155. [Google Scholar] [CrossRef]
- Calmes, B.; N’Guyen, G.; Dumur, J.; Brisach, C.A.; Campion, C.; Iacomi, B.; Pigné, S.; Dias, E.; Macherel, D.; Guillemette, T.; et al. Glucosinolate-derived isothiocyanates impact mitochondrial function in fungal cells and elicit an oxidative stress response necessary for growth recovery. Front. Plant Sci. 2015, 6, 414. [Google Scholar] [CrossRef]
- Ugolini, L.; Martini, C.; Lazzeri, L.; D’Avino, L.; Mari, M. Control of postharvest grey mould (Botrytis cinerea Per.: Fr.) on strawberries by glucosinolate-derived allyl-isothiocyanate treatments. Postharvest Biol. Technol. 2014, 90, 34–39. [Google Scholar] [CrossRef]
- Witzel, K.; Hanschen, F.S.; Schreiner, M.; Krumbein, A.; Ruppel, S.; Grosch, R. Verticillium Suppression Is Associated with the Glucosinolate Composition of Arabidopsis thaliana Leaves. PLoS ONE 2013, 8, e71877. [Google Scholar] [CrossRef]

Disclaimer/Publisher’s Note: The statements, opinions and data contained in all publications are solely those of the individual author(s) and contributor(s) and not of MDPI and/or the editor(s). MDPI and/or the editor(s) disclaim responsibility for any injury to people or property resulting from any ideas, methods, instructions or products referred to in the content. |
© 2023 by the authors. Licensee MDPI, Basel, Switzerland. This article is an open access article distributed under the terms and conditions of the Creative Commons Attribution (CC BY) license (https://creativecommons.org/licenses/by/4.0/).
Share and Cite
Sarfraz, M.; Nasim, M.J.; Gruhlke, M.C.H.; Handzlik, J.; Jacob, C. To Cut the Mustard: Antimicrobial Activity of Selenocyanates on the Plate and in the Gas Phase. Antibiotics 2023, 12, 290. https://doi.org/10.3390/antibiotics12020290
Sarfraz M, Nasim MJ, Gruhlke MCH, Handzlik J, Jacob C. To Cut the Mustard: Antimicrobial Activity of Selenocyanates on the Plate and in the Gas Phase. Antibiotics. 2023; 12(2):290. https://doi.org/10.3390/antibiotics12020290
Chicago/Turabian StyleSarfraz, Muhammad, Muhammad Jawad Nasim, Martin C. H. Gruhlke, Jadwiga Handzlik, and Claus Jacob. 2023. "To Cut the Mustard: Antimicrobial Activity of Selenocyanates on the Plate and in the Gas Phase" Antibiotics 12, no. 2: 290. https://doi.org/10.3390/antibiotics12020290
APA StyleSarfraz, M., Nasim, M. J., Gruhlke, M. C. H., Handzlik, J., & Jacob, C. (2023). To Cut the Mustard: Antimicrobial Activity of Selenocyanates on the Plate and in the Gas Phase. Antibiotics, 12(2), 290. https://doi.org/10.3390/antibiotics12020290

